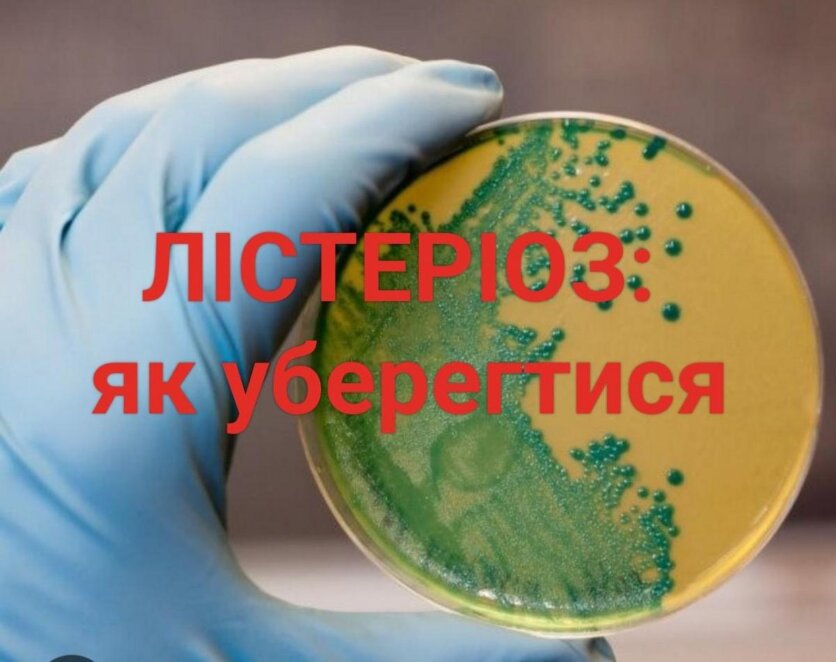

У квітні 2025 року у Кривому Розі було зареєстровано перший за останні 8 років випадок лістеріозу. Захворів 11-річний хлопчик (за іншими джерелами – підліток 2013 року народження), у якого хвороба проявилася симптомами, схожими на харчове отруєння. Стан дитини стабілізували, вона проходить лікування в обласній лікарні, спостерігається позитивна динаміка одужання, пише «Наше місто».
За інформацією «Суспільне.Дніпро», медики обстежили також батьків дитини, однак інфекцію виявили лише у хлопчика. Точно встановити, де і коли він міг заразитися, наразі неможливо.
Після появи скарг на самопочуття дитину госпіталізували до інфекційного відділення в Кривому Розі.

«Захворювання у нього проявилось за добу до госпіталізації. Стан був тяжкий, спостерігались ознаки менінгоенцефаліту», — повідомила Олена Партоєва, заступниця медичного директора з інфекційних хвороб Криворізької міської лікарні №1.
Це вже другий випадок лістеріозу, зареєстрований в Україні у 2025 році (перший був у березні в Закарпатській області). У Кривому Розі подібний випадок востаннє фіксували у 2017 році.
Симптоми лістеріозу залежать від форми захворювання і можуть варіюватися від легких гастроентеритних проявів до важких інвазивних уражень.
Основні симптоми лістеріозу
Неінвазивна форма (гастроентерит):
- лихоманка
- діарея (рідкі випорожнення з домішками слизу, іноді крові)
- нудота, блювання (може бути з домішками жовчі)
- біль у животі спастичного характеру
- головний біль
- міалгія (м’язовий біль)
- загальна слабкість і розбитість
- іноді висип на шкірі (розеоли, петехії)
Інкубаційний період – від кількох днів до 2-4 тижнів.
Інвазивна форма (важка, з ураженням ЦНС та сепсисом):
- висока лихоманка
- сильний м’язовий біль
- симптоми септицемії (загального зараження крові)
- менінгіт, менінгоенцефаліт (головний біль, ригідність потилиці, порушення свідомості)
- у вагітних – ризик аборту або внутрішньоутробного інфікування плода
- у деяких випадках – жовтяниця, гепатит, пневмонії
- висип (великі елементи на обличчі, суглобах)
- загальна млявість, загальмованість, порушення апетиту
Інкубаційний період може тривати від кількох днів до 90 днів.
Початкові симптоми часто нагадують харчове отруєння:
слабкість, озноб, підвищена температура, діарея, блювання
Лікарі наголошують, що лістеріоз – небезпечна інфекція, особливо для дітей, вагітних та людей із ослабленим імунітетом. Джерелами інфекції можуть бути дикі гризуни, сільськогосподарські тварини, дикі тварини, бродячі коти і собаки, дикі птахи, голуби. Також небезпечна бактерія може бути в м’ясі, рибі, овочах, фруктах, воді відкритих водойм, ґрунті, піску, молоці, також на посуді носія чи хворого.
Таким чином, випадок у Кривому Розі підтверджує спорадичний характер захворюваності на лістеріоз в Україні, однак наголошує на необхідності дотримання санітарно-гігієнічних норм для профілактики цього небезпечного захворювання.
Нагадаємо, раніше ми писали: У Дніпропетровській області «швидка» врятувала чоловіка, який порізав собі руку болгаркою. Впала і вдарилася головою об батарею: у Дніпрі 10-річний хлопчик врятував мамі життя.
Читайте також: Герої у білих халатах: як у Дніпрі працює екстрена медична допомога під час війни.
Цілодобово рятують життя з вірою у Перемогу: як у війну працює лікарня швидкої допомоги Дніпра.
Фото: «Суспільне.Дніпро», з відкритих джерел.
Категорія: Новини Дніпра, Новини здоров'я Дніпра, Суспільні та соціальні новини Дніпра
Позначки: Здоров'я




